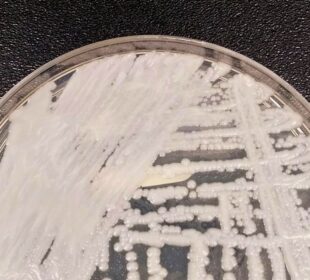

Author: cotiatododia
CULTURA PROMOVE “ESCUTA” PARA ELABORAÇÃO DE EDITAIS
Encontro contará com segmento artístico para elaboração de editais;. Objetivo é seguir com o ‘Diálogo Cultural’ que visa discutir a Lei Paulo ...13 de junho de 2023VAGAS DE EMPREGO – CONFIRA
VENDEDOR JÚNIOR A editora Manole, especializada em conteúdos técnicos, científicos e profissionais, está à procura de um vendedor júnior. Os requisitos incluem ensino ...13 de junho de 2023MOSCAS VOLANTES: O QUE SÃO OS PONTINHOS PRESENTES NA VISÃO?
Especialistas explicam o que são os irritantes pontinhos que aparecem na visão – as “moscas volantes” e o que fazer para amenizar ...12 de junho de 2023PARAPAN DE JOVENS: 45 MEDALHAS E 25 OUROS
Brasileiros chegam a 45 medalhas e 25 ouros nos Jogos Parapan-Americanos de Jovens, em Bogotá O Brasil chegou a 45 medalhas na ...12 de junho de 2023SÃO PAULO CONFIRMA PRIMEIRO CASO DE SUPERFUNGO CANDIDA AURIS
Paciente está internado em Campinas e tem boa evolução clínica; rastreamento mostrou que até agora, nenhum profissional ou paciente foi diagnosticado com ...12 de junho de 2023AUTISMO: PLANO DE SAÚDE DEVE COBRIR MUSICOTERAPIA COMO TRATAMENTO
A ministra Nancy Andrighi, do Superior Tribunal de Justiça, destacou a importância de terapias multidisciplinares para indivíduos com transtornos globais de desenvolvimento. ...12 de junho de 2023Pis/Pasep: veja pagamento do abono salarial em junho
Neste mês, pagamento do Pis/Pasep começa no dia 15 de junho. O pagamento do abono salarial PIS/Pasep de 2023, referente ao ano-base ...12 de junho de 2023TAYLOR SWIFT NO BRASIL: INGRESSOS COMEÇAM A SER VENDIDOS
Até 4 ingressos poderão ser adquiridos por CPF. Vendas começam nesta segunda, a partir das 10 horas; shows serão em São Paulo ...12 de junho de 2023DIA MUNDIAL DO OCEANO DESTACA NECESSIDADE DE PROTEGER
Data é celebrada em 8 de junho; secretário-geral das Nações Unidas cita tratados que buscam conservar ecossistema, mas afirma que é necessário “compromisso coletivo”; ...12 de junho de 2023FGTS: TRABALHADOR JÁ AGUARDA SUA COTA NO LUCRO BILIONÁRIO
Neste ano, a Caixa Econômica Federal fará distribuição de lucro bilionário na contas do trabalhador, até o mês de agosto. Trabalhadores receberão ...12 de junho de 2023
Mais Lidas
©2022 Cotia Todo Dia. Todos os direitos reservados.